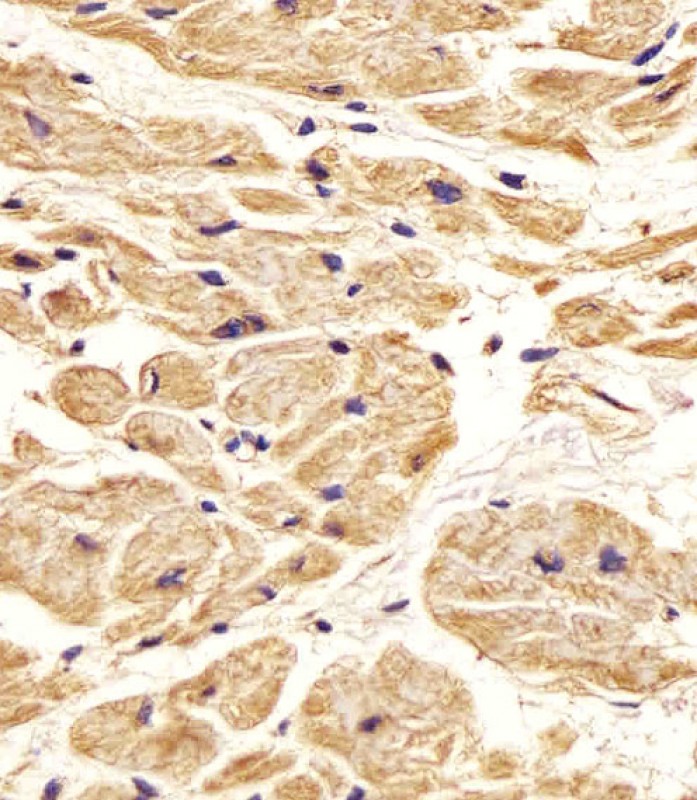
Rabbit anti-Nestin Polyclonal Antibody(S1409)

Rabbit anti-Nestin Polyclonal Antibody(S1409)描述别名宿主特异性反应种属应用分子量类型同种型储存/保存方法存储溶液研究领域背景说明UniProt参考文献
| 概述 | |
| 描述 |
Peptide AffinityPurified Rabbit Polyclonal Antibody (Pab) |
| 别名 |
Nestin抗体;Nestin; NES
|
| 宿主 |
Rabbit
|
| 特异性 |
This Nestin antibody is generated from rabbits immunized with a KLH conjugated synthetic peptide between 1389-1416 amino acids from human Nestin.
|
| 反应种属 |
Human
|
| 应用 |
FC~~1:25
IHC-P~~1:25 WB~~1:2000 IF~~1:200 |
| 分子量 |
Predicted molecular weight: 177kD
Disclaimer note: The observed molecular weight of the protein may vary from the listed predicted molecular weight due to post translational modifications, post translation cleavages, relative charges, and other experimental factors. |
| 性能 | |
| 类型 |
Polyclonal Antibody
|
| 同种型 |
Rabbit Ig
|
| 储存/保存方法 |
Maintain refrigerated at 2-8°C for up to 2 weeks. For long time storage store at -20°C in small aliquots to prevent freeze-thaw cycles.
|
| 存储溶液 |
Purified polyclonal antibody supplied in PBS with 0.09% (W/V) sodium azide. This antibody is purified through a protein A column, followed by peptide affinity purification.
|
| 研究领域 |
Cancer;Cardiovascular;Developmental Biology;Neuroscience;Signal Transduction
|
| 靶标 | |
| 背景说明 |
Required for brain and eye development. Promotes the disassembly of phosphorylated vimentin intermediate filaments (IF) during mitosis and may play a role in the trafficking and distribution of IF proteins and other cellular factors to daughter cells during progenitor cell division. Required for survival, renewal and mitogen-stimulated proliferation of neural progenitor cells (By similarity).
|
| UniProt |
P48681
|
| 参考文献 | |
| 参考文献 |
References for protein
1.Yaworsky, P.J., et al., Dev. Biol. 205(2):309-321 (1999). 2.Dahlstrand, J., et al., J. Cell. Sci. 103 (Pt 2), 589-597 (1992). References for SY5Y (SH-SY5Y; ATCC#CRL-2266): 1. Ross RA, et al. Coordinate morphological and biochemical interconversion of human neuroblastoma cells. J. Natl. Cancer Inst. 71: 741-749, 1983. [PubMed: 6137586]; 2. Biedler JL, et al. Multiple neurotransmitter synthesis by human neuroblastoma cell lines and clones. Cancer Res. 38: 3751-3757, 1978. [PubMed: 29704]. |
实验结果图

Overlay histogram showing SH-SY5Y cells stained with JP104234 (green line). The cells were fixed with 2% paraformaldehyde (10 min) and then permeabilized with 90% methanol for 10 min. The cells were then icubated in 2% bovine serum albumin to block non-specific protein-protein interactions followed by the antibody (JP104234, 1:25 dilution) for 60 min at 37ºC. The secondary antibody used was Goat-Anti-Rabbit IgG, DyLight® 488 Conjugated Highly Cross-Adsorbed(NA168821) at 1/400 dilution for 40 min at 37ºC. Isotype control antibody (blue line) was rabbit IgG (1μg/1×10^6 cells) used under the same conditions. Acquisition of >10, 000 events was performed.
JP104234 staining Nestin in Human heart tissue sections by Immunohistochemistry (IHC-P – paraformaldehyde-fixed, paraffin-embedded sections). Tissue was fixed with formaldehyde and blocked with 3% BSA for 0. 5 hour at room temperature; antigen retrieval was by heat mediation with a citrate buffer (pH6). Samples were incubated with primary antibody (1/25) for 1 hours at 37°C. A undiluted biotinylated goat polyvalent antibody was used as the secondary antibody.

Anti-Nestin Antibody (S1409) at 1:2000 dilution + Hela whole cell lysateLysates/proteins at 20 µg per lane. SecondaryGoat Anti-Rabbit IgG, (H+L), Peroxidase conjugated at 1/10000 dilution. Predicted band size : 177 kDaBlocking/Dilution buffer: 5% NFDM/TBST.

Anti-Nestin Antibody (S1409)at 1:2000 dilution + Hela whole cell lysatesLysates/proteins at 20 µg per lane. SecondaryGoat Anti-Rabbit IgG, (H+L), Peroxidase conjugated at 1/10000 dilutionPredicted band size : 177 kDaBlocking/Dilution buffer: 5% NFDM/TBST.

Fluorescent confocal image of SY5Y cells stained with Nestin (S1409) antibody. SY5Y cells were fixed with 4% PFA (20 min), permeabilized with Triton X-100 (0.2%, 30 min). Cells were then incubated with JP104234 Nestin (S1409) primary antibody (1:200, 2 h at room temperature). For secondary antibody, Alexa Fluor® 488 conjugated donkey anti-rabbit antibody (green) was used (1:1000, 1h). Nuclei were counterstained with Hoechst 33342 (blue) (10 μg/ml, 5 min). Note the highly specific localization of the Nestin (S1409) immunosignal to the intermediate filaments, supported by Human Protein Atlas Data (http://www.proteinatlas.org/ENSG00000132688).

Western blot analysis of Nestin Antibody (S1409) (Cat.#JP104234) in HepG2 cell line lysates (35ug/lane). NES (arrow) was detected using the purified Pab.

Formalin-fixed and paraffin-embedded human hepatocarcinoma reacted with Nestin Antibody (S1409), which was peroxidase-conjugated to the secondary antibody, followed by DAB staining. This data demonstrates the use of this antibody for immunohistochemistry; clinical relevance has not been evaluated.
